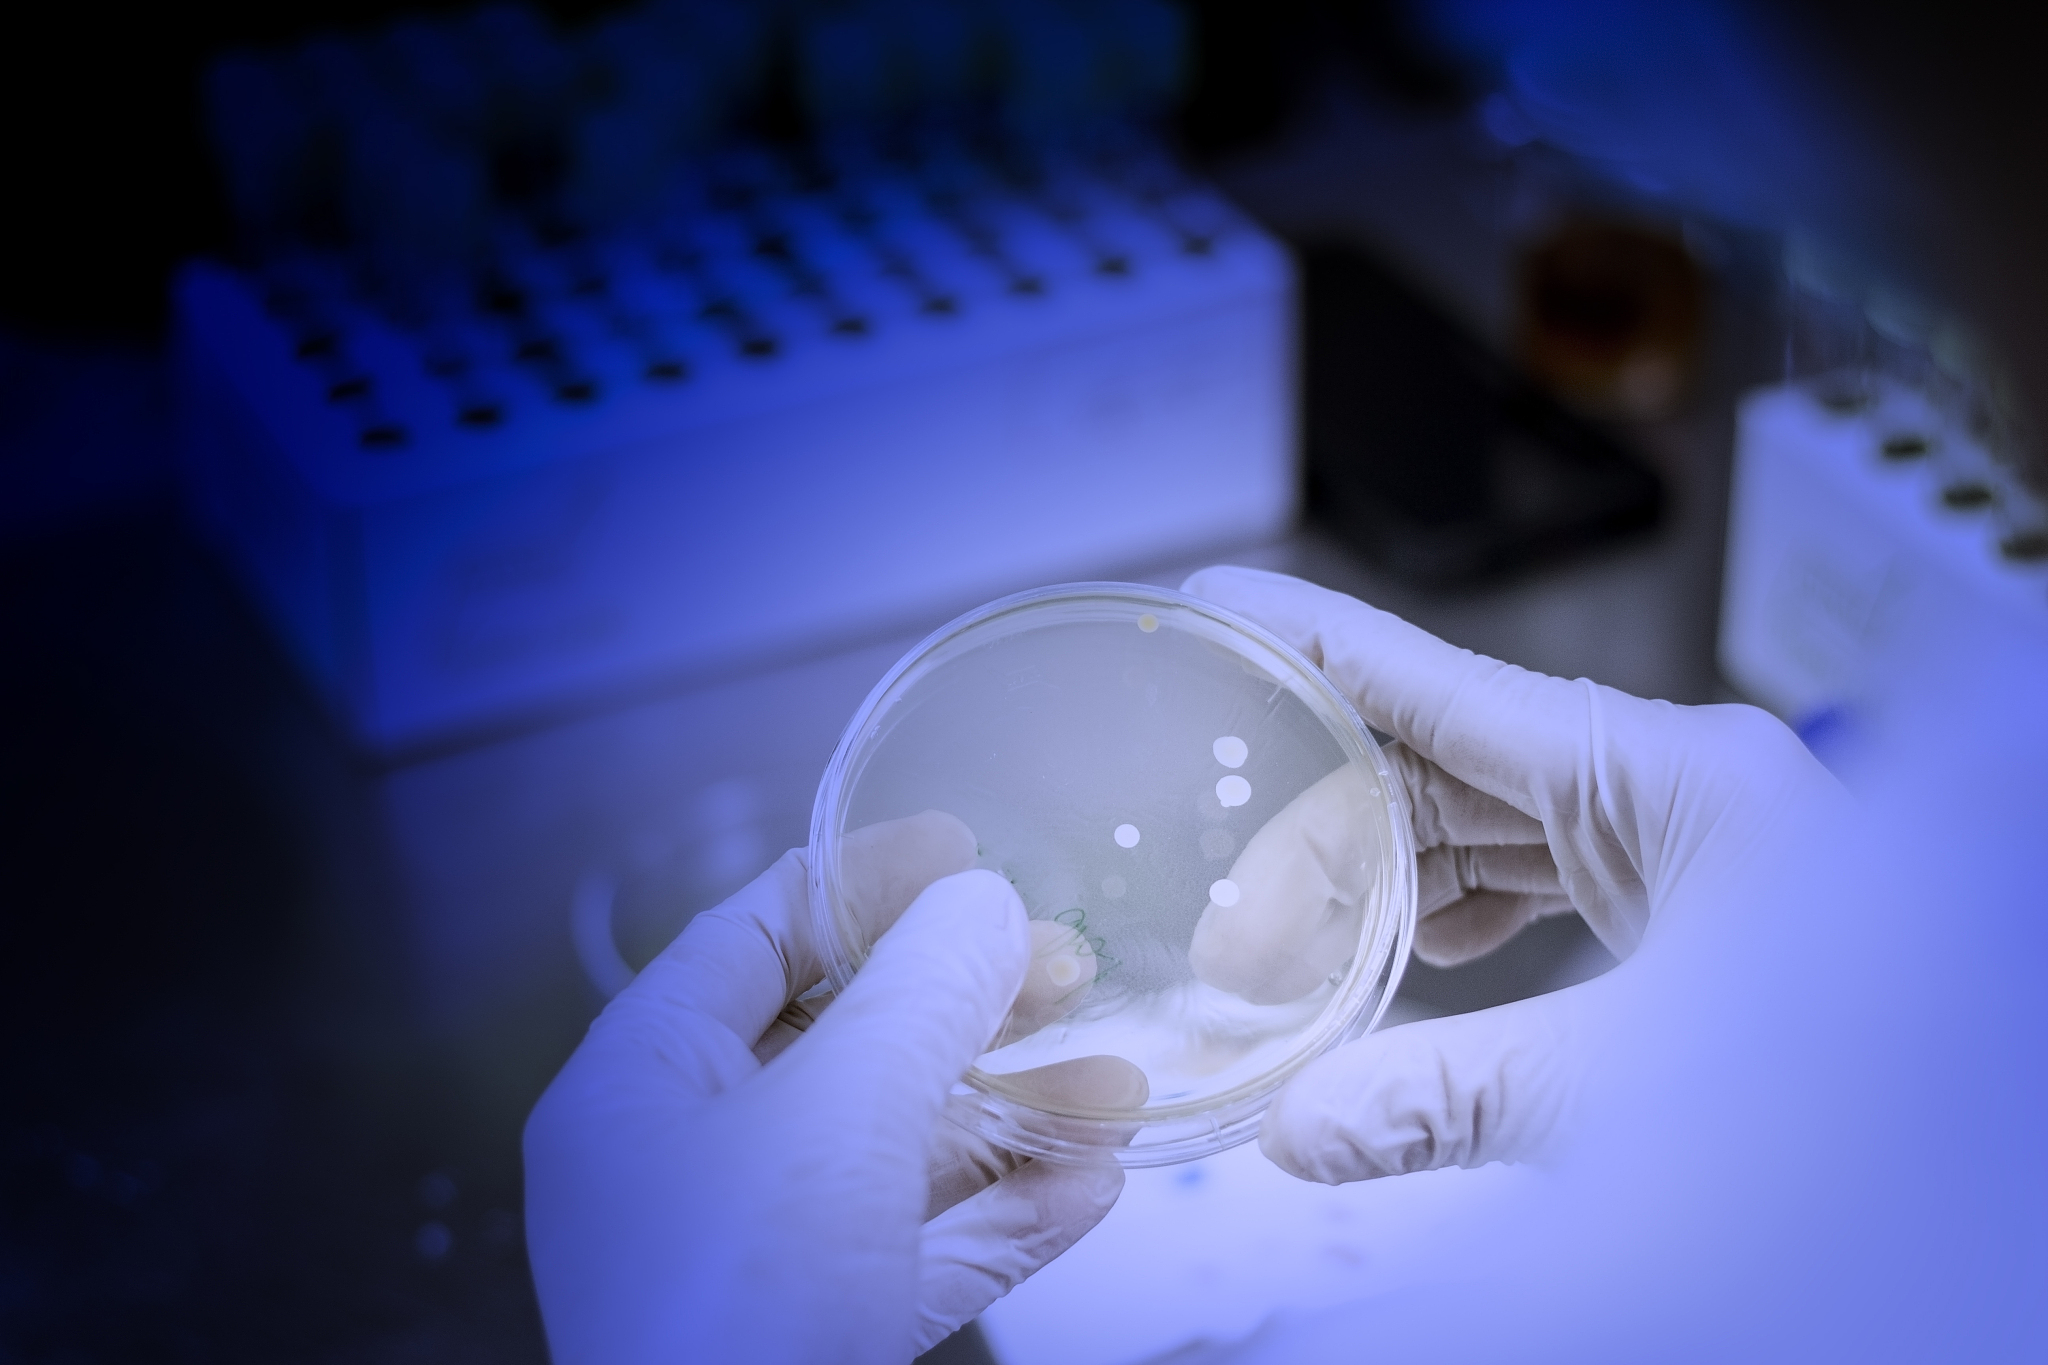
北京林业大学生物科学类专业怎么样

北京林业大学生物科学类专业怎么样
北京林业大学生物科学类专业的优势与不足
北京林业大学生物科学类专业是该校的重点学科之一,也是许多考生和家长关注的热门专业。这个专业到底怎么样呢?今天我们就来探讨一下。
首先,北京林业大学生物科学类专业的优势在于其教学质量和师资力量。该校拥有一批高水平的教授和博士,他们不仅在学术研究方面有着丰富的经验和成果,而且在教学方面也表现出色。学生们可以在这里接受到系统、全面的生物科学知识,并获得实践经验,为今后的发展打下坚实的基础。
其次,该专业的课程设置也十分丰富多样。学生可以选择自己感兴趣的方向进行深入学习和研究,比如植物学、动物学、微生物学、生态学等等。这不仅有利于学生的个性化发展,也有助于他们在未来选择职业方向时更加明确自己的兴趣和优势。
然而,北京林业大学生物科学类专业也存在一些不足之处。首先是就业前景方面,虽然生物科学类专业在国内外都有着广泛的应用和需求,但是就业市场竞争也非常激烈,特别是对于没有硕士及以上学位的本科生来说,就业压力较大。其次是学科发展方向的单一性,虽然该专业涵盖了多个方向,但是在具体学科发展方向上,相对单一,缺乏多元化的发展。
综上所述,北京林业大学生物科学类专业既有其优势,也有其不足之处。对于考生和家长而言,选择该专业需要全面考虑自身兴趣和职业规划,做好充分的准备和规划,才能在未来的发展道路上走得更加稳健和顺利。
####################
北京林业大学生物科学类专业
北京林业大学生物科学类专业是一门涵盖植物学、动物学、微生物学、生态学等多个方向的综合性学科,它的发展与生物科学的进步密不可分。作为该校的重点学科之一,该专业在教学质量和师资力量方面表现突出,拥有一批高水平的教授和博士,他们的教学和研究成果在国内外都有着广泛的影响和应用。
该专业的课程设置丰富多样,学生可以根据自己的兴趣和职业规划选择不同的方向进行深入学习和研究。例如,对于对植物学感兴趣的学生,可以选择学习植物分类学、植物生理学、植物生态学等课程;对于对动物学感兴趣的学生,可以选择学习动物行为学、动物生态学、动物系统学等课程。这不仅有利于学生的个性化发展,也有助于他们在未来选择职业方向时更加明确自己的兴趣和优势。
然而,该专业也存在一些不足之处。首先是就业前景方面,虽然生物科学类专业在国内外都有着广泛的应用和需求,但是就业市场竞争也非常激烈,特别是对于没有硕士及以上学位的本科生来说,就业压力较大。其次是学科发展方向的单一性,虽然该专业涵盖了多个方向,但是在具体学科发展方向上,相对单一,缺乏多元化的发展。
因此,对于考生和家长而言,选择北京林业大学生物科学类专业需要全面考虑自身兴趣和职业规划,做好充分的准备和规划,才能在未来的发展道路上走得更加稳健和顺利
原文地址: https://www.cveoy.top/t/topic/do4F 著作权归作者所有。请勿转载和采集!